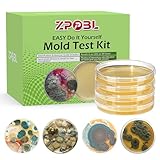
Mold Test Kit for Home, 4 Detection Tests for HVAC, Surfaces & Indoor Air Quality, DIY Black Home Mold Detector Testing kit, Identification Guide & Free Lab Analysis Included

10 Best At Home Mold Kit of 2026
Related Deals You Might Like for At Home Mold Kit
Here's what we found:

Our overall winner is Mold Test Kit for Home - 12 Simple Detection Tests,Test HVAC System,Home Surfaces,& Indoor Air Quality Testing Kits,DIY Mold Detector at Home,Includes Detailed Mold Identification Guide,air Tester by KAYENQO. It stands out for the right balance of quality, performance and value.

The best value for most shoppers is Mold Test Kit for Home Within 12 Individual Tests,DIY Detector at Home, Surface Mold,HVAC,Indoor Air Quality Testing Kits,Black Mold Testing,Includes Detailed Mold Identification Guide and Free Lab by Entimp, with consistently high satisfaction across expert and customer reviews.

The strongest deal right now for At Home Mold Kit is Healthful Home 5-Minute Mold Test. Aspergillus/Penicillium and Stachybotrys. Works Even If You Can't See The Mold. No More Waiting for Labs. Includes Expert Consultation. at Healthful Home, currently at 21% off.